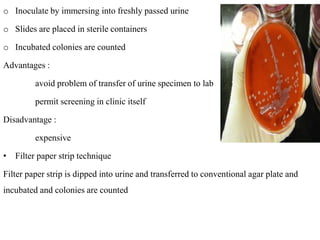
o Inoculate by immersing into freshly passed urine
o Slides are placed in sterile containers
o Incubated colonies are counted
Advantages :
avoid problem of transfer of urine specimen to lab
permit screening in clinic itself
Disadvantage :
expensive
• Filter paper strip technique
Filter paper strip is dipped into urine and transferred to conventional agar plate and
incubated and colonies are counted

This document defines and describes urinary tract infections (UTIs). It discusses the types of UTIs including upper and lower tract infections. It outlines predisposing factors like age, sex, pregnancy, and structural abnormalities. It describes the typical organisms that cause UTIs like E. coli. The document discusses pathogenesis, clinical features, complications, and laboratory diagnosis of UTIs including specimen collection and screening tests. Culture remains the most accurate diagnostic method.